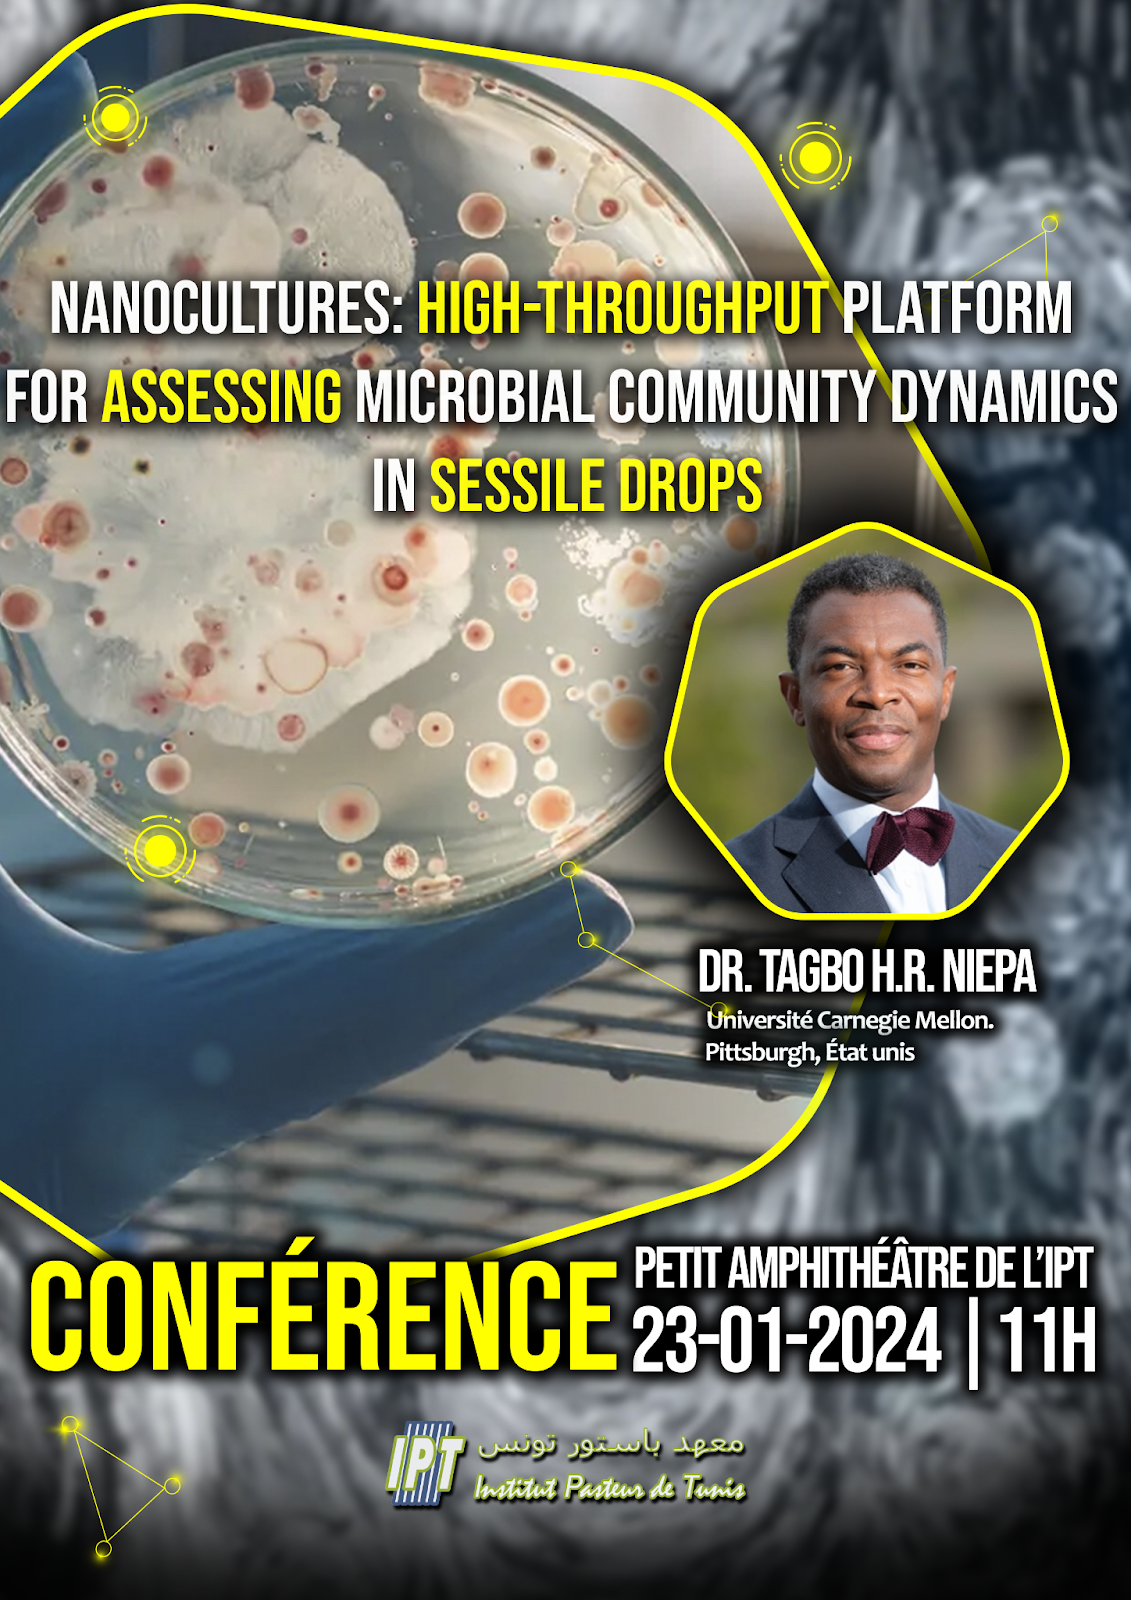

Actualités

- Détails
- By institutpasteur
- Affichages : 1531
Le vingt-troisième séminaire de l'IPT, intitulé "Strategies for improving expression of Recombinant Human Chorionic Gonadotropin in Chinese Hamster Ovary (CHO) cells", sera assuré par Mr. Iheb BOUKARI, Doctorant au Laboratoire de microbiologie moléculaire, vaccinologie et développement biotechnologique,

- Détails
- By institutpasteur
- Affichages : 743
Une conférence passionnante intitulée "Harnessing systems biology for advancing knowledge on fungal virulence and discovery of new antifungals", est prévue pour le lundi 15 avril 2024 à 10h00.

- Détails
- By institutpasteur
- Affichages : 670
Dans le cadre du "Centre régional de formation (RTC/IPT-TDR/OMS)", un cours intitulé "Good Clinical Practice/ Good Clinical Laboratory Practice (French version)" se tiendra à Hammamet du 09 au 11 Mai 2024.

- Détails
- By institutpasteur
- Affichages : 747
Nous avons le plaisir de vous informer que la Société Tunisienne de Pathologie Infectieuse et l’Institut Pasteur de Tunis co-organisent une formation intitulée : "Séquençage et Caractérisation Moléculaire des Génomes viraux : de la Théorie à la Pratique".

- Détails
- By institutpasteur
- Affichages : 509
L’équipe responsable de la gestion du cluster de calcul à haute performance (HPC) de l’Institut Pasteur de Tunis, organise une demi journéealtd’information (mini workshop) autour du cluster de calcul institutionnel mis en place dans le cadre du projet PHINDaccess et financé par le ministère de l’enseignement supérieur et la recherche scientifique (MESRS).

- Détails
- By institutpasteur
- Affichages : 550
Le vingt-deuxième séminaire de l'IPT, intitulé "Identification du profil mutationnel associé aux formes héréditaires du carcinome gastrique en Tunisie", sera assuré par le Dr. Jihenne BEN AISSA-HAJ, Docteur en sciences biologiques au Laboratoire de Génomique Biomédicale et Oncogénétique (LBGMO), service d’Anatomie Pathologique à l’Institut Pasteur de Tunis.

- Détails
- By institutpasteur
- Affichages : 539
Venez assister à une conférence captivante intitulée" Revue diligente: comment valoriser une nouvelle entité moléculaire (NEM)" présentée par le Professeur François-Xavier Lacasse de la Faculté de Pharmacie de l'Université de Montréal.

- Détails
- By institutpasteur
- Affichages : 724
L'Institut Pasteur de Tunis organise dans le cadre des activités de formation du projet PerMediNA "Personalized Medicine in North Africa" l'Académie de Médecine de Précision (PMA) dans sa 2ème Édition du 15 au 18 Avril 2024 à Tunis.

- Détails
- By institutpasteur
- Affichages : 860
L'Institut Pasteur de Tunis (IPT) a stratégiquement accueilli les réunions pour le lancement des cadres de mise en œuvre du Consortium Africain des Leishmanioses (ALC), en préparation du lancement officiel de ses activités de recherche et de formation, à son siège à Tunis, du 26 au 28 février 2024.

- Détails
- By institutpasteur
- Affichages : 421
Pour dynamiser la collaboration entre les différentes équipes de l'Institut et renforcer l'interaction des compétences existantes sur le campus pasteurien, le Conseil Scientifique de l'Institut Pasteur de Tunis a créé en 2012 les Programmes Collaboratifs Internes (PCI).

- Détails
- By institutpasteur
- Affichages : 471
Au cours de cet évènement, plus de 112 participants tunisiens ont bénéficié de consultations gratuites en gériatrie, endocrinologie, neurologie, psychiatrie et sciences de la nutrition
- Détails
- By institutpasteur
- Affichages : 785
Une conférence passionnante est prévue pour le mardi 23 janvier 2024 à 11h00.
Cet événement se déroulera dans le petit amphithéâtre du bâtiment de recherche de l'Institut Pasteur de Tunis.

- Détails
- By institutpasteur
- Affichages : 821
La Société Francophone de Médecine Tropicale et de Santé Internationale (SFMTSI) organise, en partenariat, entre autres, avec l’Institut Pasteur de Tunis, le congrès « Santé en Méditerranée » qui aura lieu du 22 au 24 Mai 2024 à Saint-Raphaël, France.

- Détails
- By institutpasteur
- Affichages : 468
L'Institut Pasteur de Tunis (IPT) a le plaisir d'annoncer la tenue de la Réunion de lancement du projet ALLIANCE SHS AFRIQUE en Tunisie, le jeudi 14 décembre 2023 à 9h30 dans le grand amphithéâtre de l'IPT.

- Détails
- By institutpasteur
- Affichages : 427
La conférence "Leishmaniasis: Field-to-Lab & Lab-to-Field" sera présentée par le Dr. Hirotomo Kato, de la Division de Zoologie Médicale du Département des Infections et de l'Immunité de l'Université médicale Jichi au Japon.

- Détails
- By mehdimrad
- Affichages : 669
Le vingt et unième séminaire de l'IPT intitulé : Recherche sur les biomolécules actives issues de venin de serpent comme alternative thérapeutique pour la santé humaine

- Détails
- By mehdimrad
- Affichages : 572
We are pleased to announce the 3rd Bioinformatics event organized as part of the activities of the German-Arab Research Network for Computational Life Science (GARN-CLS) and entitled “The Power of Data: Bioinformatics Applications in Healthcare”.

- Détails
- By anouarsgaier
- Affichages : 379
L'Institut Pasteur de Tunis lance DisintegrinDB, la première base de données intégrative référençant les désintégrines, petites protéines non enzymatiques issues de venins de serpents.

- Détails
- By mehdimrad
- Affichages : 487
Le Comité d'Éthique Biomédicale (CEBM) de l'Institut Pasteur de Tunis reprend son activité de formation en éthique de la recherche biomédicale.

- Détails
- By mehdimrad
- Affichages : 572
The Clinical Virology Laboratory at the Institut Pasteur de Tunis, serving as the WHO Regional Reference Laboratory (RRL) for Poliomyelitis and Measles/Rubella surveillance,
Plus d'articles...
- Lancement du Réseau Africain d'Oncogénétique
- Dr Emna FEHRI nommée et élue membre de la prestigieuse Société d’honneur Américaine « SIGMA Xi »
- Matinée Scientifique de Sensibilisation à l'Occasion de la Journée Mondiale du Diabète
- Genomic Surveillance and Characterization of Microbial Threats Facilitates Early Detection and Containment of Disease Outbreaks in West Africa




